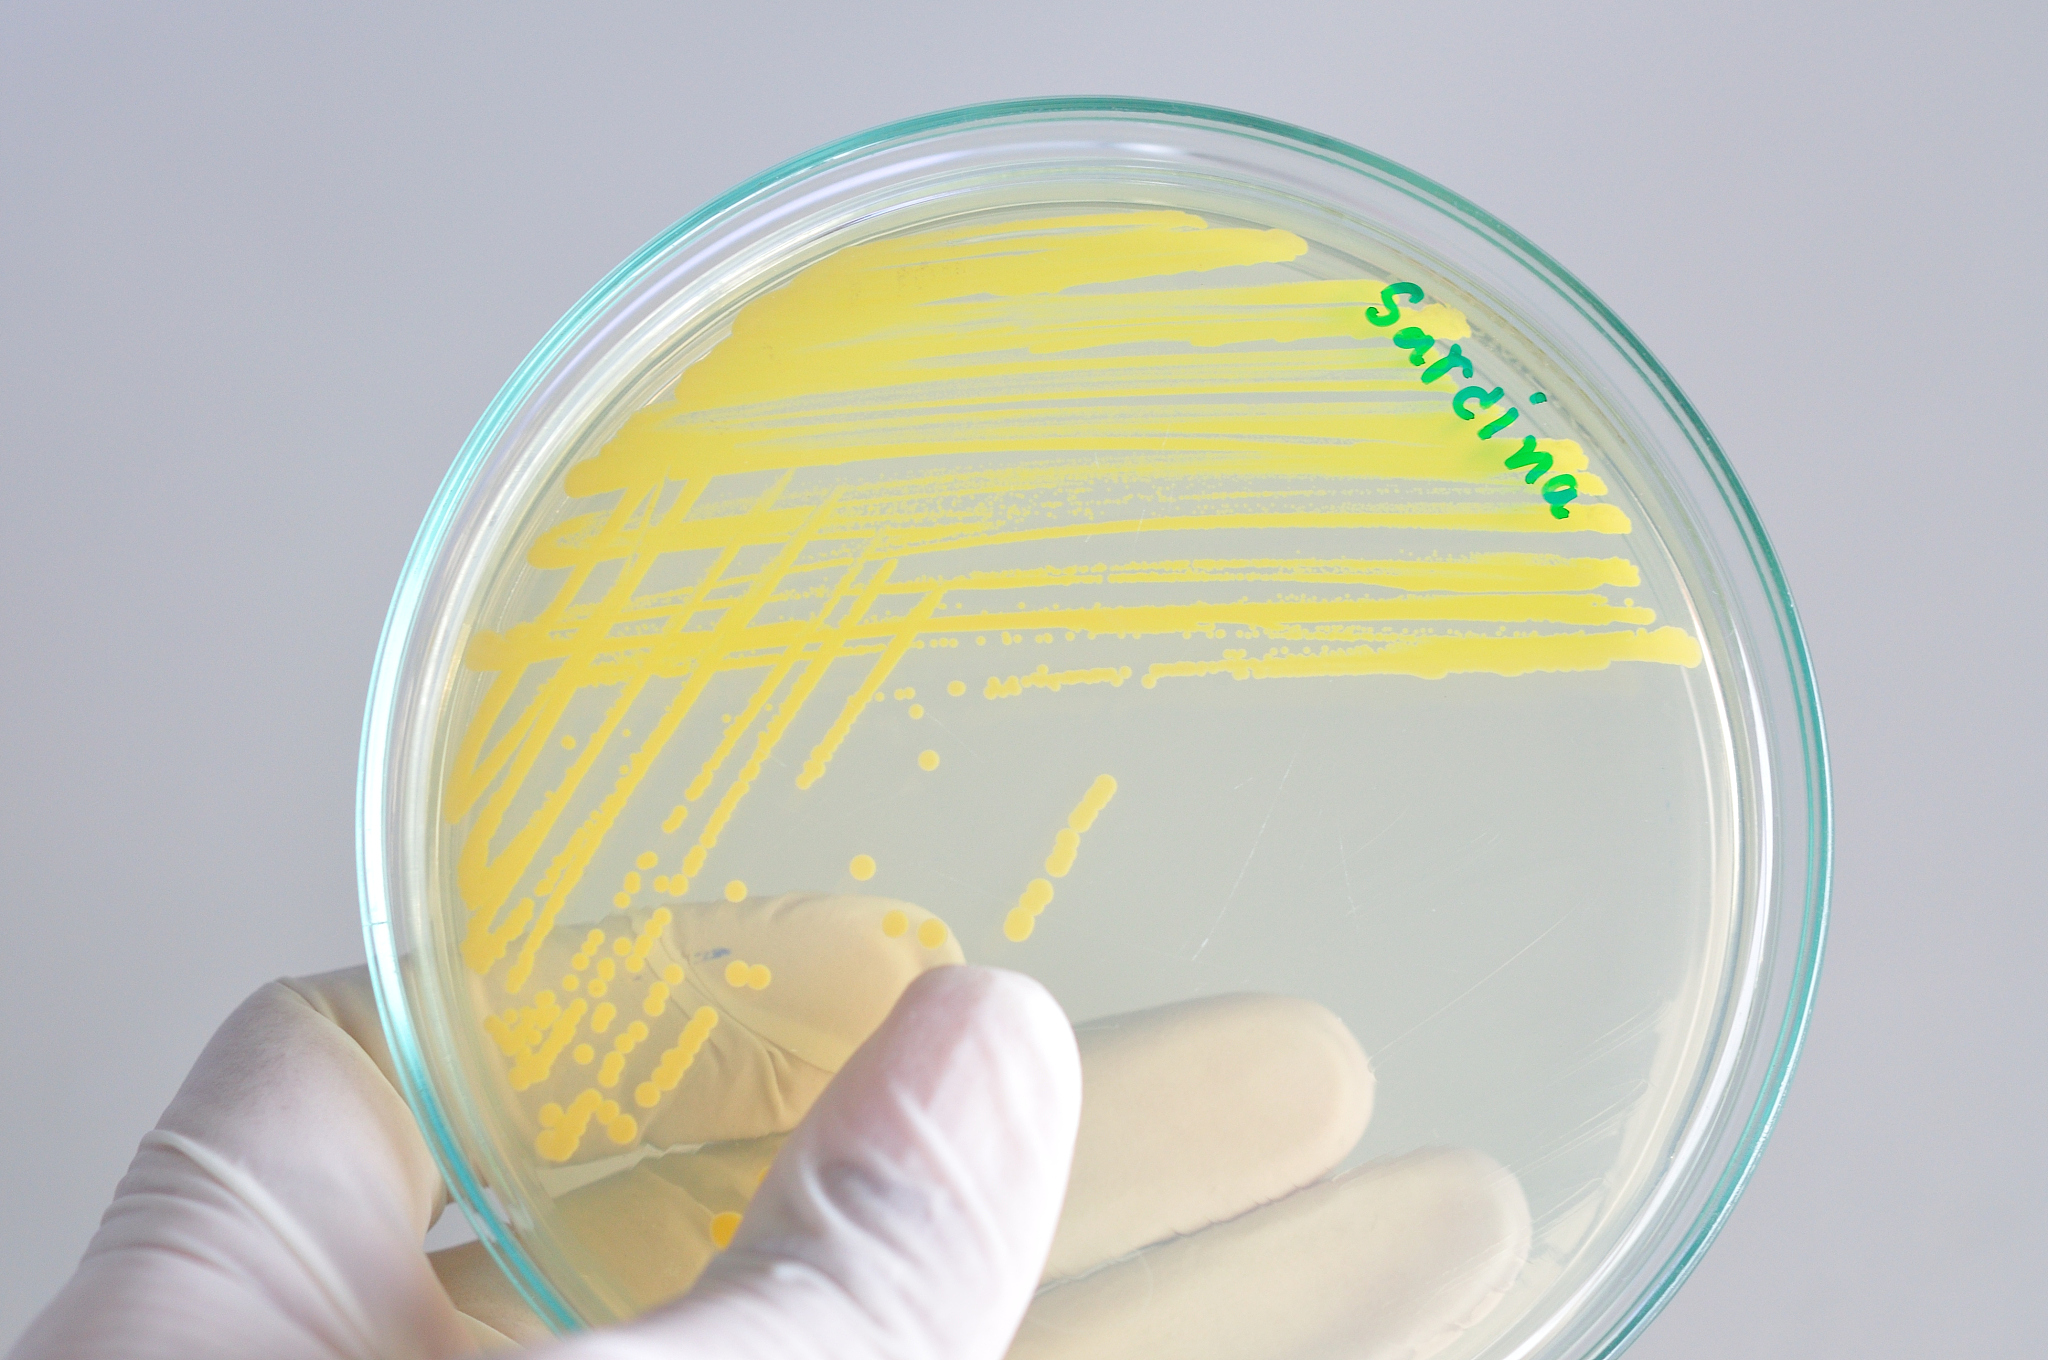
细菌胞外蛋白酶培养基选择指南

细菌胞外蛋白酶培养基选择指南
要收集细菌产生的胞外蛋白酶,应选择适合细菌生长和蛋白酶产生的培养基。具体选择哪种培养基可以根据目标细菌的类型和环境条件进行考虑。以下是几种常用的培养基类型:
-
营养琼脂培养基:这是最常见的培养基类型之一,适用于多种细菌的生长。它提供了丰富的碳源、氮源和其他必需营养物质,可以促进菌体生长和胞外蛋白酶的产生。
-
蛋白胨培养基:这种培养基富含蛋白胨(蛋白质水解物),可以为细菌提供丰富的氮源和营养物质。蛋白胨培养基常用于研究细菌产生胞外酶的能力和特性。
-
蛋白质酶解培养基:这种培养基特别设计用于促进细菌产生胞外蛋白酶。它包含一些特定的蛋白质底物或肽链,作为诱导剂来刺激细菌产生酶。
-
特定底物培养基:有时,为了收集特定类型的胞外蛋白酶,可以选择适合该酶底物的特定培养基。例如,用于收集蛋白酶A的培养基可能包含合适的底物(如酪蛋白)来诱导蛋白酶A的产生。
此外,根据目标细菌的生境和生长条件,还可以考虑调整培养基的pH值、温度、氧气水平和其他环境因素。这样可以更好地创造一个有利于细菌生长和胞外蛋白酶产生的环境。
最终的选择应根据具体的研究目的和细菌特性进行评估。在实验设计中,需要进行多组对照实验和重复实验,以确保数据的可靠性和实验结果的可重复性。
原文地址: https://www.cveoy.top/t/topic/bNs2 著作权归作者所有。请勿转载和采集!